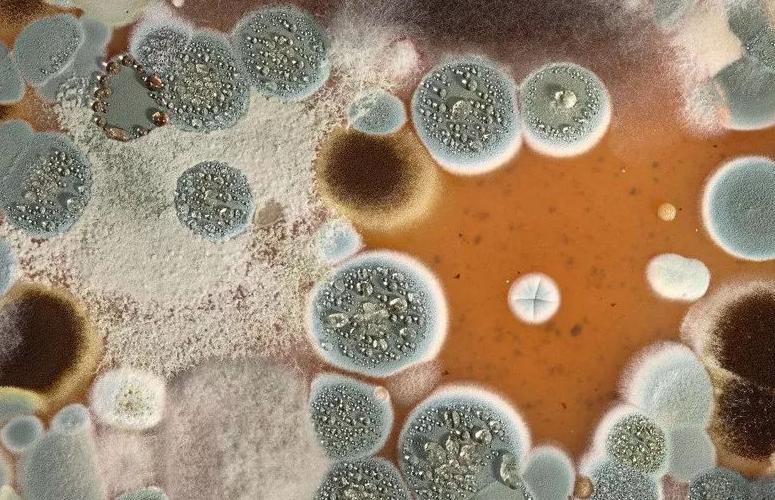
被世卫公认的一级致癌物是啥,一级致癌物被曝光

随着生活水平的提高,人们不再只关心吃饱饭,更多的是将目光放在健康饮食方面,关注食物质量是否合格,是否有细菌、寄生虫的出现。
于是相关的食品质量检测中心陆陆续续的出现,但这些检测中心的检测对象是市面上的一些正处于销售的已加工的商品

对于一些市场上新鲜蔬果类食物、人们自己种植或处理的食物依旧有着一定危害身体健康的可能。
而被世界卫生组织评定为一级致癌物的黄曲霉素,则广泛存在于变质、发霉食物或是处理不当的食物中。
黄曲霉素分离出多种黄曲霉毒素及20多种衍生物,其中包括B1、B2、G1、G2、M1等毒素和毒醇。
1.什么是黄曲霉毒素?
黄曲霉毒素是黄曲霉素的一种,会在80%~90%的相对湿度以及25℃~30℃的温度条件下生长出,并且难溶于水,性质较为稳定。 有着极强的致突变性,致癌性。
虽然目前已经采用不产生毒素的黄曲霉毒素播撒在土壤中,作为防治作物,抑制微生物、黄曲霉毒素生长的手段,但黄曲霉毒素依旧是一级致癌物,有着巨大的毒性。

2.黄曲霉素有多毒?
(1) 毒性大
作为一级致癌物,黄曲霉毒素的毒性极强, 他的毒性比常见的剧毒氰化氢要强10倍,比*霜砒**强68倍 ,仅次于肉毒霉素,是霉菌中毒性最强的。
易在发生霉变食物中滋生,随着人们的食用进入机体,对人体的造成极大伤害。
(2) 中毒剂量小
只要人体内黄曲霉毒素的摄入量 超过1 mg,就会引起DNA的病变 ,抑制蛋白质的合成,进而损害肝脏,使肝脏出现出血性坏死、脂肪变性或肝硬化等一系列疾病,摄入量更多的则会诱发肝癌。
之前就有这么一个案例,70多岁的方阿姨年轻时过着苦日子过惯了,即使现在被儿子接到城里过好日子养老了,也依旧改不了一些过于节俭的习惯。
对一些发霉的玉米、变味的肉、发苦的花生也舍不得扔,想着洗洗,晒晒太阳就能吃了。
病从口入,就是这些舍不得粮食,不愿意浪费粮食的行为,让方阿姨被确诊为肝癌,省着这些小钱,却花着治疗的大钱。

3.黄曲霉素主要存在于哪些食物中?
黄曲霉毒素除了存在于上述案例中所 包括的发霉的玉米、变味的肉、发苦的花生 这些变质的谷物、坚果外,在久泡的木耳、反复使用的食用中也大量存在。
这是因为不管是因为存放时间过长,存放环境湿度过高而发霉变质的食物,还是浸泡时间太久的木耳、反复使用的食用油,都有着适宜黄曲霉毒素 生长温度、湿度条件 。
并且由于黄曲霉毒素耐高温,一旦生长,常规的烹饪方式或是晒太阳的方法都无法将其破坏。

4.黄曲霉毒素中毒表现是什么?
(1) 慢性中毒
在长期小剂量摄入黄曲霉毒素时,就会表现出慢性中毒现象,主要的病理变化为与 肝脏 相关的慢性损伤,如肝硬化、肝脂肪变性等;也会使生长发育变得迟缓,降低体重。
(2) 急性中毒
若一次摄入量过多时,则表现为急性中毒,主要侵害的器官就是肝脏,会出现肝脏出血性坏死、急性肝炎、肝实质细胞脂肪增生、胆管增生等情况。
(3) 诱发肝癌
如果没有停止摄入黄曲霉毒素,或没有在出现毒性反应时及时接受治疗,则有可能诱发肝癌,在早期出现 消瘦,呕吐,瞳孔、皮肤发黄 等现象,严重时会出现 腹水、下肢水肿,甚至死亡。
历史上较为严重的一起黄曲霉毒素中毒案例,则是在1974年的印度西部,当时印度某个地区的多个村庄的村民都以玉米为主食,但却赶上雨季泛滥,玉米严重发霉变质,
当地的村民依旧食用霉变的玉米, 造成397人中毒,106人死亡 ,在之后的尸检报告中也证明此次的中毒甚至死亡事件是由于黄曲霉毒素引起的。

5.如何预防黄曲毒素霉中毒?
因此,拒绝食用这些发霉、变质的食物尤其重要。那么我们在日常生活该如何预防黄曲霉毒素中毒呢?
(1) 注意食物保鲜
首先可以根据黄曲霉毒素是生长条件入手,黄曲霉毒素的生长必不可缺的一个条件就是水分。这里的水分是指可以与食物中的小分子结合的结合水,结合水越多,就越容易滋生黄曲霉毒素。
而存放时间越长,食物中的小分子与空气中的水分结合越多,或是粮食存放的环境过于潮湿、湿度过大,食物中的小分子就越易与空气中的水分结合。
(2) 避免木耳长时间浸泡
并且在进行木耳烹饪前,木耳需要用水浸泡,但要注意木耳的浸泡时间不宜过长,否则会变成良好的黄曲霉毒素的培养皿,黄曲霉毒素会大量滋生,随着食用进入人体,危害人体健康。
因此,我们要注意食物的新鲜或注意食物的保鲜,尽量在购入食物短期内就将其烹饪,无法及时烹饪的可以存放于密闭、低温、低湿度的环境中。
(3) 丢弃发霉食物
其次,如若食物还是出现发霉、变质的情况,就要果断丢弃,不要秉持珍惜粮食的心理,将霉变食物的霉菌清洗后继续食用。
因为即使表面的霉菌被清洗掉,食物依旧会携带黄曲霉毒素进入人体内。
(4) 判断黄曲霉毒素
如果无法辨别食物是否发生霉变的,可以进行试吃,因为黄曲霉毒素有巨大苦味,如果食用后,感觉很苦的,需要立即吐出,并及时漱口。
(5) 选择正规食用油,并合理使用
并且,不要反复使用或使用已出现霉变的食用油,在购买食用油时要选择正规的食品厂家。
这是因为不论是花生油还是玉米油,都是由谷物烹炸、提取出的,其中的淀粉含量丰富,在长期使用时,与空气大面积接触,
其中的淀粉分子会与空气中的水分结合产生霉变,滋生黄曲霉毒素;也会因为储存、运输不当滋生霉菌。

6.黄曲霉毒素急性中毒后措施
如果依旧出现黄曲霉毒素急性中毒现象,如 皮肤发黄胃痛胃胀、腹部肿大、下肢水肿甚至呼吸困难、昏迷等症状,也不要过于慌张 ,及时将患者送往医院或拨打急救电话,
跟医生说明情况后, 进行药物催吐、服用利尿药或是洗胃的方式, 将体内的黄曲霉毒素从机体中排出即可;
如果出现严重中毒现象,如黄疸、肝脏出血性坏死、急性肝炎,甚至肝癌的一些早期症状,则需要在医生的指导下服用保肝利胆药物,必要时还需要进行手术治疗。
引用文献:
[1]龚敏,陈明亮,金鹏,纪少凡,王朝政,李备.QuEChERS结合UPLC—MS/MS测定水产品中4种黄曲霉毒素及其裂解规律研究[J/OL].热带农业科学:1-8[2023-05-10].
[2]曹本男,郭璞.2种HPLC-柱后衍生化-荧光检测法测定远志中黄曲霉毒素的比较[J].工业微生物,2023,53(02):132-135.